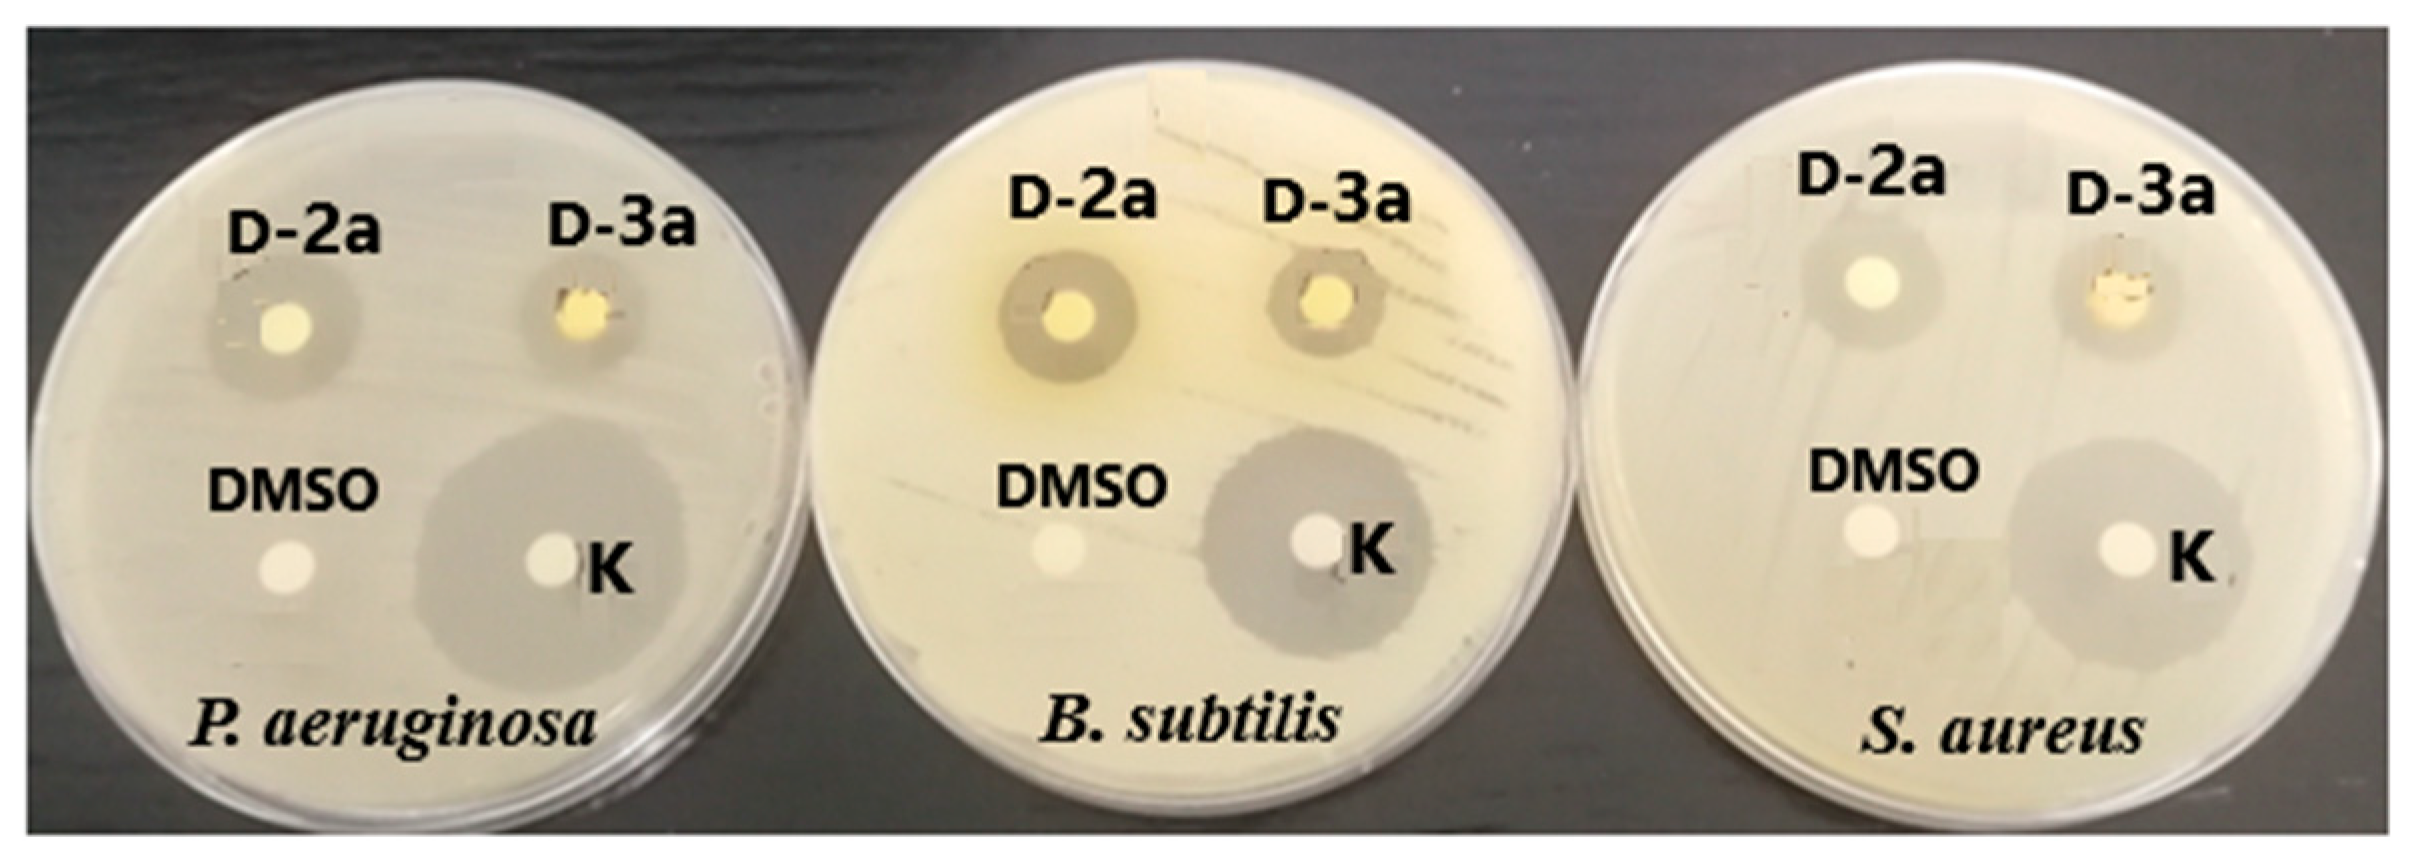
Inorganics 11 00029 g009 Inorganics 11 00029 g009

Biological Evaluation and Conformational Preferences of Ferrocene Dipeptides with Hydrophobic Amino Acids
Abstract
1. Introduction
2. Results and Discussion
2.1. Infrared (IR), Nuclear Magnetic Resonance (NMR) and Circular Dichroism (CD) Studies
2.2. Computational Study
2.3. X-ray Crystal Structure Analysis
2.4. Biological Evaluation
2.4.1. Antimicrobial Activity
2.4.2. Antioxidant Activity
2.5. Hydrophobicity
2.6. Proteolytic Stability of Ferrocene Peptides
3. Materials and Methods
3.1. Conformational Analysis
3.2. Computational Details
3.3. X-ray Diffraction
3.4. Antimicrobial Activity
3.5. Antioxidant Activity Assays
3.6. Statistical Analysis
3.7. Hydrophobicity
3.8. Chemical Stability
3.9. Proteolytic Stability
4. Conclusions
Supplementary Materials
Author Contributions
Funding
Data Availability Statement
Acknowledgments
Conflicts of Interest
References
- Herrick, R.S.; Jarret, R.M.; Curran, T.P.; Dragoli, D.R.; Flaherty, M.B.; Lindyberg, S.E.; Slate, R.A.; Thornton, L.C. Ordered conformations in bis(amino acid) derivatives of 1,1′-ferrocenedicarboxylic acid. Tetrahedron Lett. 1996, 37, 5289–5292. [Google Scholar] [CrossRef]
- Kirin, S.I.; Wissenbach, D.; Metzler-Nolte, N. Unsymmetrical 1,n′-disubstituted ferrocenoyl peptides: Convenient one pot synthesis and solution structures by CD and NMR spectroscopy. New J. Chem. 2005, 29, 1168–1173. [Google Scholar] [CrossRef]
- Barišić, L.; Rapić, V.; Metzler-Nolte, N. Incorporation of the Unnatural Organometallic Amino Acid 1′-Aminoferrocene-1-carboxylic Acid (Fca) into Oligopeptides by a Combination of Fmoc and Boc Solid-Phase Synthetic Methods. Eur. J. Inorg. Chem. 2006, 20, 4019–4021. [Google Scholar] [CrossRef]
- Čakić Semenčić, M.; Siebler, D.; Heinze, K.; Rapić, V. Bis- and Trisamides Derived From 1′-Aminoferrocene-1-carboxylic Acid and α-Amino Acids: Synthesis and Conformational Analysis. Organometallics 2009, 28, 2028–2037. [Google Scholar] [CrossRef]
- Chowdhury, S.; Mahmoud, K.A.; Schatte, G.; Kraatz, H.-B. Amino acid conjugates of 1,1′-diaminoferrocene. Synthesis and chiral organization. Org. Biomol. Chem. 2005, 3, 3018–3023. [Google Scholar] [CrossRef]
- Kovačević, M.; Kodrin, I.; Cetina, M.; Kmetič, I.; Murati, T.; Čakić Semenčić, M.; Roca, S.; Barišić, L. The conjugates of ferro-cene-1,1′-diamine and amino acids. A novel synthetic approach and conformational analysis. Dalton Trans. 2015, 44, 16405–16420. [Google Scholar] [CrossRef]
- Van Staveren, D.R.; Metzler-Nolte, N. Bioorganometallic Chemistry of Ferrocene. Chem. Rev. 2004, 104, 5931–5985. [Google Scholar] [CrossRef]
- Tharamani, C.N.; Mahmoud, K.A.; Vasanthakumar, G.R.; Kraatz, H.-B. Studies into the interaction of a ferrocene-conjugates of Gly-Gly-Arg-Tyr with papain: AC voltammetry, impedance spectroscopy and surface plasmon resonance studies. Sens. Actuators B Chem. 2009, 137, 253–258. [Google Scholar] [CrossRef]
- Kerman, K.; Kraatz, H.-B. Electrochemical probing of HIV enzymes using ferrocene-conjugated peptides on surfaces. Analyst 2009, 134, 2400–2404. [Google Scholar] [CrossRef]
- Kovačević, M.; Kodrin, I.; Roca, S.; Molčanov, K.; Shen, Y.; Adhikari, B.; Kraatz, H.-B.; Barišić, L. Helically Chiral Peptides That Contain Ferrocene-1,1′-diamine Scaffolds as a Turn Inducer. Chem. Eur. J. 2017, 23, 10372–10395. [Google Scholar] [CrossRef]
- Scully, C.C.G.; Jensen, P.; Rutledge, P.J. Mercury binding by ferrocenoyl peptides with sulfur-containing side chains: Electrochemical, spectroscopic and structural studies. J. Organomet. Chem. 2008, 693, 2869–2876. [Google Scholar] [CrossRef]
- Qing, G.-Y.; Sun, T.-L.; Wang, F.; He, Y.-B.; Yang, X. Chromogenic Chemosensors for N-Acetylaspartate Based on Chiral Ferrocene-Bearing Thiourea Derivatives. Eur. J. Org. Chem. 2009, 6, 841–849. [Google Scholar] [CrossRef]
- Moriuchi, T.; Yoshida, K.; Hirao, T. Chirality-Organized Ferrocene Receptor Bearing Podand Dipeptide Chains (−L-Ala-L-Pro-NHPyMe) for the Selective Recognition of Dicarboxylic Acids. Org. Lett. 2003, 5, 4285–4288. [Google Scholar] [CrossRef]
- Zong, Z.; Cao, Z.; Hao, A.; Xing, P. Dynamic axial chirality of ferrocene diamino acids: Hydration effects and chiroptical applications. J. Mater. Chem. C 2021, 9, 12191–12200. [Google Scholar] [CrossRef]
- Albada, B.; Metzler-Nolte, N. Highly Potent Antibacterial Organometallic Peptide Conjugates. Acc. Chem. Res. 2017, 50, 2510–2518. [Google Scholar] [CrossRef]
- Costa, N.C.S.; Piccoli, J.P.; Santos-Filho, N.A.; Clementino, L.C.; Fusco-Almeida, A.M.; De Annunzio, S.R.; Fontana, C.R.; Verga, J.B.M.; Eto, S.F.; Pizauro-Junior, J.M.; et al. Antimicrobial activity of RP-1 peptide conjugate with ferrocene group. PLoS ONE 2020, 15, e0228740. [Google Scholar] [CrossRef]
- Wenzel, M.; Chiriac, A.I.; Otto, A.; Zweytick, D.; May, C.; Schumacher, C.; Gust, R.; Albada, H.B.; Penkova, M.; Krämer, U.; et al. Small cationic antimicrobial peptides delocalize peripheral membrane proteins. Proc. Natl. Acad. Sci. USA 2014, 111, 1409–1418. [Google Scholar] [CrossRef]
- Ardila-Chantré, N.; Hernández-Cardonab, A.K.; Pineda-Castañeda, H.M.; Estupiñan-Torresb, S.M.; Leal-Castroc, A.L.; Fierro-Medina, R.; Rivera-Monroy, Z.J.; García-Castañeda, J.E. Short peptides conjugated to non-peptidic motifs exhibit antibacterial activity. RSC Adv. 2020, 10, 29580–29586. [Google Scholar] [CrossRef]
- Slootweg, J.C.; Prochnow, P.; Bobersky, S.; Bandow, J.E.; Metzler-Nolte, N. Exploring Structure-Activity Relationships in Synthetic Antimicrobial Peptides (synAMPs) by a Ferrocene Scan. Eur. J. Inorg. Chem. 2017, 2, 360–367. [Google Scholar] [CrossRef]
- Khelef, A.; Lanez, T. In vitro assays of the antioxidant activities of ferrocene derivatives bearing amine, amide or hydrazine groups. Der Pharma Chem. 2015, 7, 318–323. [Google Scholar] [CrossRef]
- Milaeva, E.R.; Filimonova, S.I.; Meleshonkova, N.N.; Dubova, L.G.; Shevtsova, E.F.; Bachurin, S.O.; Zefirov, N.S. Antioxidative Activity of Ferrocenes Bearing 2,6-Di-Tert-Butylphenol Moieties. Bioinorg. Chem. Appl. 2010, 2010, 165482. [Google Scholar] [CrossRef] [PubMed]
- Štimac, A.; Lapić, J.; Blasina, V.; Lukinac, M.; Djaković, S.; Crnolatac, I.; Frkanec, L.; Frkanec, R. Adamantyl ferrocene derivatives: Antioxidant abilities and effects on model lipid membranes. Appl. Organomet. Chem. 2017, 32, e4042. [Google Scholar] [CrossRef]
- Erckes, V.; Steuer, C. A story of peptides, lipophilicity and chromatography-back and forth in time. RSC Med. Chem. 2022, 13, 676–687. [Google Scholar] [CrossRef] [PubMed]
- Lee, A.C.; Harris, J.L.; Khanna, K.K.; Hong, J.H. A Comprehensive Review on Current Advances in Peptide Drug Development and Design. Int. J. Mol. Sci. 2019, 20, 2383. [Google Scholar] [CrossRef] [PubMed]
- Wei, C.-W.; Peng, Y.; Zhang, L.; Huang, Q.; Cheng, M.; Liu, Y.-N.; Li, J. Synthesis and evaluation of ferrocenoyl pentapeptide (Fc-KLVFF) as an inhibitor of Alzheimer’s Aβ1–42 fibril formation in vitro. Bioorg. Med. Chem. Lett. 2011, 21, 5818–5821. [Google Scholar] [CrossRef]
- Zhou, B.; Li, C.-L.; Hao, Y.-Q.; Johnny, M.C.; Liu, Y.-N.; Li, J. Ferrocene tripeptide Gly-Pro-Arg conjugates: Synthesis and inhibitory effects on Alzheimer’s Aβ1–42 fibrillogenesis and Aβ-induced cytotoxicity in vitro. Bioorg. Med. Chem. 2013, 21, 395–402. [Google Scholar] [CrossRef]
- Chen, Y.; Yang, C.; Li, T.; Zhang, M.; Liu, Y.; Gauthier, M.A.; Zhao, Y.; Wu, C. The Interplay of Disulfide Bonds, α-Helicity, and Hydrophobic Interactions Leads to Ultrahigh Proteolytic Stability of Peptides. Biomacromolecules 2015, 16, 2347–2355. [Google Scholar] [CrossRef]
- Porter, E.A.; Weisblum, B.; Gellman, S.H. Mimicry of host-defense peptides by unnatural oligomers: Antimicrobial beta-peptides. J. Am. Chem. Soc. 2002, 124, 7324–7330. [Google Scholar] [CrossRef]
- Singh, A.; Lumb, I.; Mehrac, V.; Kumar, V. Ferrocene-appended pharmacophores: An exciting approach for modulating the biological potential of organic scaffolds. Dalton Trans. 2019, 48, 2840–2860. [Google Scholar] [CrossRef]
- Sharma, B.; Kumar, V. Has Ferrocene Really Delivered Its Role in Accentuating the Bioactivity of Organic Scaffolds? J. Med. Chem. 2021, 64, 16865–16921. [Google Scholar] [CrossRef]
- Kovačević, M.; Molčanov, K.; Radošević, K.; Srček Gaurina, V.; Roca, S.; Čače, A.; Barišić, L. Conjugates of 1′-aminoferrocene-1-carboxylic acid and proline: Synthesis, conformational analysis and biological evaluation. Molecules 2014, 21, 12852–12880. [Google Scholar] [CrossRef]
- Kovačević, M.; Čakić Semenčić, M.; Radošević, K.; Molčanov, K.; Roca, S.; Šimunović, L.; Kodrin, I.; Barišić, L. Conformational Preferences and Antiproliferative Activity of Peptidomimetics Containing Methyl 1′-Aminoferrocene-1-carboxylate and Turn-Forming Homo- and Heterochiral Pro-Ala Motifs. Int. J. Mol. Sci. 2021, 22, 13532. [Google Scholar] [CrossRef]
- Čakić Semenčić, M.; Barišić, L. Ferrocene Bioconjugates. Croat. Chem. Acta 2017, 90, 537–569. [Google Scholar] [CrossRef]
- Idrees, M.; Mohammad, A.R.; Karodia, N.; Rahman, A. Multimodal Role of Amino Acids in Microbial Control and Drug Development. Antibiotics 2020, 9, 330. [Google Scholar] [CrossRef]
- van de Waterbeemd, H.; Karajiannis, H.; El Tayar, N. Lipophilicity of amino acids. Amino Acids 1994, 7, 129–145. [Google Scholar] [CrossRef]
- Kovačević, M.; Markulin, D.; Zelenika, M.; Marjanović, M.; Lovrić, M.; Polančec, D.; Ivančić, M.; Mrvčić, J.; Molčanov, K.; Milašinović, V.; et al. Hydrogen Bonding Drives Helical Chirality via 10-Membered Rings in Dipeptide Conjugates of Ferrocene-1,1′-Diamine. Int. J. Mol. Sci. 2022, 23, 12233. [Google Scholar] [CrossRef]
- Iqbal, M.; Balaram, P. The 310 helical conformation of the amino terminal decapeptide of suzukacillin. 270 MHz hydrogen-1 NMR evidence for eight intramolecular hydrogen bonds. J. Am. Chem. Soc. 1981, 103, 5548–5552. [Google Scholar] [CrossRef]
- Venkatachalapathi, Y.V.; Prasad, B.V.V.; Balaram, P. Conformational analysis of small disulfide loops. Spectroscopic and theoretical studies on a synthetic cyclic tetrapeptide containing cystine. Biochemistry 1982, 2, 5502–5509. [Google Scholar] [CrossRef]
- Stevens, E.S.; Sugawara, N.; Bonora, G.M.; Toniolo, C. Conformational analysis of linear peptides. 3. Temperature dependence of NH chemical shifts in chloroform. J. Am. Chem. Soc. 1980, 102, 7048–7050. [Google Scholar] [CrossRef]
- Patti, A.; Pedotti, S.; Mazzeo, G.; Longhi, G.; Abbate, S.; Paoloni, L.; Bloino, J.; Rampino, S.; Barone, V. Ferrocenes with simple chiral substituents: An in-depth theoretical and experimental VCD and ECD study. Phys. Chem. Chem. Phys. 2019, 21, 9419–9432. [Google Scholar] [CrossRef]
- Nuskol, M.; Šutalo, P.; Đaković, M.; Kovačević, M.; Kodrin, I.; Čakić Semenčić, M. Testing the Potential of the Ferrocene Chromophore as a Circular Dichroism Probe for the Assignment of the Screw-Sense Preference of Tripeptides. Organometallics 2021, 40, 1351–1362. [Google Scholar] [CrossRef]
- Čakić Semenčić, M.; Kodrin, I.; Barišić, L.; Nuskol, M.; Meden, A. Synthesis and Conformational Study of Monosubstituted Aminoferrocene-Based Peptides Bearing Homo- and Heterochiral Pro-Ala Sequences. Eur. J. Inorg. Chem. 2017, 2, 306–317. [Google Scholar] [CrossRef]
- Barišić, L.; Kovačević, M.; Mamić, M.; Kodrin, I.; Mihalić, Z.; Rapić, V. Synthesis and Conformational Analysis of Methyl N-Alanyl-1′-aminoferrocene-1-carboxylate. Eur. J. Inorg. Chem. 2012, 11, 1810–1822. [Google Scholar] [CrossRef]
- Čakić Semenčić, M.; Kovač, V.; Kodrin, I.; Barišić, L.; Rapić, V. Synthesis and Conformational Study of Bioconjugates Derived from 1-Acetyl-1′-aminoferrocene and α-Amino Acids. Eur. J. Inorg. Chem. 2015, 1, 112–123. [Google Scholar] [CrossRef]
- Lapić, J.; Djaković, S.; Kodrin, I.; Mihalić, Z.; Cetina, M.; Rapić, V. Preparation and Conformation Analysis of N-(Ferrocenoyl)Dipeptide Esters and Their 1′-Acetyl Derivatives. Eur. J. Org. Chem. 2010, 13, 2512–2524. [Google Scholar] [CrossRef]
- Kovačević, M.; Rapić, V.; Lukač, I.; Molčanov, K.; Kodrin, I.; Barišić, L. Novel Fully Protected Muramic Acid: A Facile Synthesis and Structural Study. J. Mol. Struct. 2013, 1048, 349–356. [Google Scholar] [CrossRef]
- Djaković, S.; Kodrin, I.; Smrečki, V.; Novak, P.; Mihalić, Z.; Žiher, D.; Lapić, J.; Rapić, V. 1′-Acetylferrocene Amino Acid Esters and Amides. A Simple Model for Parallel β-Helical Peptides. Tetrahedron 2014, 70, 2330–2342. [Google Scholar] [CrossRef]
- Nuskol, M.; Studen, B.; Meden, A.; Kodrin, I.; Čakić Semenčić, M. Tight Turn in Dipeptide Bridged Ferrocenes: Synthesis, X-ray Structural, Theoretical and Spectroscopic Studies. Polyhedron 2019, 161, 137–144. [Google Scholar] [CrossRef]
- Nuskol, M.; Šutalo, P.; Kodrin, I.; Semenčić, M.Č. Sensing of the Induced Helical Chirality by the Chiroptical Response of the Ferrocene Chromophore. Eur. J. Inorg. Chem. 2022, 2, e202100880. [Google Scholar] [CrossRef]
- Kovač, V.; Kodrin, I.; Radošević, K.; Molčanov, K.; Adhikari, B.; Kraatz, H.-B.; Barišić, L. Oxalamide-Bridged Ferrocenes: Conformational and Gelation Properties and In Vitro Antitumor Activity. Organometallics 2022, 41, 920–936. [Google Scholar] [CrossRef]
- Čakić Semenčić, M.; Kodrin, I.; Molčanov, K.; Kovačević, M.; Rapić, V. Novel Ferrocene Imide Derivatives: Synthesis, Conformational Analysis and X-ray Structure. Heliyon 2022, 8, e09470. [Google Scholar] [CrossRef]
- Farrugia, L.J. ORTEP-3 for Windows-a version of ORTEP-III with a Graphical User Interface (GUI). J. Appl. Cryst. 1997, 30, 565. [Google Scholar] [CrossRef]
- Boto, A.; Pérez de la Lastra, J.M.; González, C.C. The Road from Host-Defense Peptides to a New Generation of Antimicrobial Drugs. Molecules 2018, 23, 311. [Google Scholar] [CrossRef]
- Zhang, J.; Fu, Y.; Yang, P.; Liu, X.; Li, Y.; Gu, Z. ROS Scavenging Biopolymers for Anti-Inflammatory Diseases: Classification and Formulation. Adv. Mater. Interfaces 2020, 7, 2000632. [Google Scholar] [CrossRef]
- Lee, T.H.; Hall, K.N.; Aguilar, M.I. Antimicrobial peptide structure and mechanism of action: A focus on the role of membrane structure. Curr. Top. Med. Chem. 2016, 6, 25–39. [Google Scholar] [CrossRef]
- Li, J.; Koh, J.J.; Liu, S.; Lakshminarayanan, R.; Verma, C.S.; Beuerman, R.W. Membrane active antimicrobial peptides: Translating mechanistic insights to design. Front. Neurosci. 2017, 11, 73. [Google Scholar] [CrossRef]
- Schmidtchen, A.; Pasupuleti, M.; Malmsten, M. Effect of hydrophobic modifications in antimicrobial peptides. Adv. Colloid Interface Sci. 2014, 205, 265–274. [Google Scholar] [CrossRef]
- Kataoka, H. Sample Preparation for Liquid Chromatography. In Liquid Chromatography: Applications, 2nd ed.; Fanali, S., Haddad, P., Poole, C., Riekkola, M.-L., Eds.; Elsevier: Amsterdam, The Netherlands, 2017; pp. 1–37. [Google Scholar]
- Fekete, S.; Veuthey, J.L.; Guillarme, D. New trends in reversed-phase liquid chromatographic separations of therapeutic peptides and proteins: Theory and applications. J. Pharm. Biomed. Anal. 2012, 69, 9–27. [Google Scholar] [CrossRef]
- Neuhaus, C.S.; Gabernet, G.; Steuer, C.; Hiss, J.A.; Zenobi, R.; Schneider, G. Simulated Molecular Evolution for Anticancer Peptide Design. Angew. Chem. Int. Ed. 2019, 58, 1674–1678. [Google Scholar] [CrossRef]
- Shibue, M.; Mant, C.T.; Hodges, R.S. Effect of anionic ion-pairing reagent hydrophobicity on selectivity of peptide separations by reversed-phase liquid chromatography. J. Chromatogr. A 2005, 1080, 68–75. [Google Scholar] [CrossRef]
- Frederiksen, N.; Hansen, P.R.; Björkling, F.; Franzyk, H. Peptide/Peptoid Hybrid Oligomers: The Influence of Hydrophobicity and Relative Side-Chain Length on Antibacterial Activity and Cell Selectivity. Molecules 2019, 24, 4429. [Google Scholar] [CrossRef] [PubMed]
- Pirisinu, M.; Blasco, P.; Tian, X.; Sen, Y.; Bode, A.M.; Liu, K.; Dong, Z. Analysis of hydrophobic and hydrophilic moments of short penetrating peptides for enhancing mitochondrial localization: Prediction and validation. FASEB J. 2019, 33, 7970–7984. [Google Scholar] [CrossRef]
- Medina-Alarcón, K.P.; Singulani, J.L.; Voltan, A.R.; Sardi, J.C.O.; Petrônio, M.S.; Santos, M.B.; Polaquini, C.R.; Regasini, L.O.; Bolzani, V.S.; da Silva, D.H.S.; et al. Alkyl Protocatechuate-Loaded Nanostructured Lipid Systems as a Treatment Strategy for Paracoccidioides brasiliensis and Paracoccidioides lutzii In Vitro. Front. Microbiol. 2017, 8, 1048–1060. [Google Scholar] [CrossRef] [PubMed]
- Pace, C.N.; Fu, H.; Fryar, K.L.; Landua, J.; Trevino, S.R.; Schell, D.; Thurlkill, R.L.; Imura, S.; Scholtz, J.M.; Gajiwala, K.; et al. Contribution of hydrogen bonds to protein stability. Protein Sci. 2014, 23, 652–661. [Google Scholar] [CrossRef] [PubMed]
- Lu, J.; Xu, H.; Xia, J.; Ma, J.; Xu, J.; Li, Y.; Feng, J. D- and Unnatural Amino Acid Substituted Antimicrobial Peptides with Improved Proteolytic Resistance and Their Proteolytic Degradation Characteristics. Front. Microbiol. 2020, 11, 563030. [Google Scholar] [CrossRef]
- Schrödinger, LLC. MacroModel; Schrödinger, LLC: New York, NY, USA, 2019. [Google Scholar]
- Mohamadi, F.; Richards, N.G.J.; Guida, W.C.; Liskamp, R.; Lipton, M.; Caufield, C.; Chang, G.; Hendrickson, T.; Still, W.C. Macromodel—An integrated software system for modeling organic and bioorganic molecules using molecular mechanics. J. Comput. Chem. 1990, 11, 440–467. [Google Scholar] [CrossRef]
- Frisch, M.J.; Trucks, G.W.; Schlegel, H.B.; Scuseria, G.E.; Robb, M.A.; Cheeseman, J.R.; Scalmani, G.; Barone, V.; Petersson, G.A.; Nakatsuji, H.; et al. Gaussian 16, revision C.01; Gaussian, Inc.: Wallingford, CT, USA, 2016.
- Becke, A.D. Density-functional thermochemistry. III. The role of exact exchange. J. Chem. Phys. 1993, 98, 5648–5652. [Google Scholar] [CrossRef]
- Lee, C.; Yang, W.; Parr, R.G. Development of the Colle-Salvetti correlation-energy formula into a functional of the electron density. Phys. Rev. B 1998, 37, 785–789. [Google Scholar] [CrossRef]
- Grimme, S.; Antony, J.; Ehrlich, S.; Krieg, H. A consistent and accurate ab initio parameterization of density functional dispersion correction (DFT-D) for the 94 elements H-Pu. J. Chem. Phys. 2010, 132, 154104. [Google Scholar] [CrossRef]
- Marenich, A.V.; Cramer, C.J.; Truhlar, D.G. Universal solvation model based on solute electron density and a continuum model of the solvent defined by the bulk dielectric constant and atomic surface tensions. J. Phys. Chem. B 2009, 113, 6378–6396. [Google Scholar] [CrossRef]
- Keith, T.A. AIMAll, version 19.02.13; TK Gristmill Software: Overland Park, KS, USA, 2017.
- Koch, U.; Popelier, P.L.A. Characterization of C-H-O Hydrogen Bonds on the Basis of the Charge Density. J. Phys. Chem. 1995, 99, 9747–9754. [Google Scholar] [CrossRef]
- Rigaku Corporation. CrysAlis, version 1.171.42.69a; Rigaku Oxford Diffraction Ltd.: Yarnton, UK, 2022. [Google Scholar]
- Sheldrick, G.M. SHELXT-integrated space-group and crystal-structure determination. Acta Crystallogr. A Found. Adv. 2015, 71, 3–8. [Google Scholar] [CrossRef]
- Sheldrick, G.M. Crystal structure refinement with SHELXL. Acta Crystallogr. C 2015, 71, 3–8. [Google Scholar] [CrossRef]
- Farrugia, L.J. WinGX and ORTEP for Windows: An update. J. Appl. Cryst. 2012, 45, 849–854. [Google Scholar] [CrossRef]
- Spek, A.L. CheckCIF validation ALERTS: What they mean and how to respond. Acta Crystallogr. 2020, 76, 1–11. [Google Scholar] [CrossRef]
- Macrae, C.F.; Sovago, I.; Cottrell, S.J.; Galek, P.T.A.; McCabe, P.; Pidcock, E.; Platings, M.; Shields, G.P.; Stevens, J.S.; Towler, M.; et al. Mercury 4.0: From visualization to analysis, design and prediction. J. Appl. Cryst. 2020, 53, 226–235. [Google Scholar] [CrossRef]
- Balouiri, M.; Sadiki, M.; Ibnsouda, S.K. Methods for in vitro evaluating antimicrobial activity: A review. J. Pharm. Anal. 2016, 6, 71–79. [Google Scholar] [CrossRef]

| δ (ppm) | ||||||
|---|---|---|---|---|---|---|
| d-1a | d-1b | d-2a | d-2b | d-3a | d-3b | |
| NHFca | 8.19 | 7.38 | 8.15 | 7.62 | 7.73 | 7.32 |
| NHAA | 6.46 | 5.15 | 6.38 | 5.03 | 6.44 | 5.15 |
| Compound | Test Microorganisms | Molarity of Solutions for Disk Diffusion Method (mM) | Inhibition Zone (mm) | MIC (mM) |
|---|---|---|---|---|
| d-1a | S. aureus | 251 | nd | >2 |
| B. subtilis | 7 ± 1 | >2 | ||
| P. aeruginosa | nd | >2 | ||
| d-2a | S. aureus | 243 | 16 ± 1 | >2 |
| B. subtilis | 16 ± 1 | >2 | ||
| P. aeruginosa | 19 ± 2 | >2 | ||
| d-3a | S. aureus | 224 | 14 ± 1 | >2 |
| B. subtilis | 14 ± 1 | >2 | ||
| P. aeruginosa | 14 ± 1 | >2 | ||
| Kanamycin | S. aureus | 50 µg disk | 25 ± 0 | nd |
| B. subtilis | 25 ± 0 | nd | ||
| P. aeruginosa | 28 ± 1 | nd |
| Compound (1 mM) | DPPH (% Inhibition) | DPPH (mM Trolox Equivalent) | FRAP (mM Trolox) |
|---|---|---|---|
| l-1b | 11.75 ± 2.10 | 0.150 | 2.16 ± 0.013 |
| l-2b | 16.55 ± 1.77 | 0.211 | 2.27 ± 0.006 |
| l-3b | 5.50 ± 3.87 | 0.067 | 1.62 ± 0.001 |
| d-1b | 7.76 ± 0.65 | 0.099 | 2.17 ± 0.015 |
| d-2b | 8.79 ± 2.10 | 0.112 | 2.21 ± 0.003 |
| d-3b | 3.99 ± 0.48 | 0.051 | 2.00 ± 0.001 |
| l-1a | 4.57 ± 0.64 | 0.058 | 0.58 ± 0.009 |
| l-2a | 3.19 ± 1.29 | 0.041 | 0.72 ± 0.004 |
| l-3a | 3.65 ± 2.26 | 0.046 | 1.09 ± 0.030 |
| d-1a | 10.62 ± 1.13 | 0.135 | 2.29 ± 0.003 |
| d-2a | 6.96 ± 0.81 | 0.089 | 1.77 ± 0.001 |
| d-3a | 5.25 ± 2.26 | 0.067 | 2.22 ± 0.006 |
| Standard (0.5 mM Trolox) | 39.27 ± 8.40 | 0.500 |
| Compound | tR/min | % ACN |
|---|---|---|
| l-1b | 7.1 | 82.6 |
| l-2b | 8.3 | 87.5 |
| l-3b | 8.3 | 87.9 |
| d-1b | 7.1 | 82.6 |
| d-2b | 8.3 | 87.5 |
| d-3b | 8.3 | 87.9 |
| l-1a | 2.6 | 63.7 |
| l-2a | 3.3 | 66.6 |
| l-3a | 3.6 | 68.0 |
| d-1a | 2.6 | 63.7 |
| d-2a | 3.3 | 66.6 |
| d-3a | 3.6 | 68.0 |
Disclaimer/Publisher’s Note: The statements, opinions and data contained in all publications are solely those of the individual author(s) and contributor(s) and not of MDPI and/or the editor(s). MDPI and/or the editor(s) disclaim responsibility for any injury to people or property resulting from any ideas, methods, instructions or products referred to in the content. |
© 2023 by the authors. Licensee MDPI, Basel, Switzerland. This article is an open access article distributed under the terms and conditions of the Creative Commons Attribution (CC BY) license (https://creativecommons.org/licenses/by/4.0/).
Share and Cite
Kovačević, M.; Čakić Semenčić, M.; Kodrin, I.; Roca, S.; Perica, J.; Mrvčić, J.; Stanzer, D.; Molčanov, K.; Milašinović, V.; Brkljačić, L.; et al. Biological Evaluation and Conformational Preferences of Ferrocene Dipeptides with Hydrophobic Amino Acids. Inorganics 2023, 11, 29. https://doi.org/10.3390/inorganics11010029
Kovačević M, Čakić Semenčić M, Kodrin I, Roca S, Perica J, Mrvčić J, Stanzer D, Molčanov K, Milašinović V, Brkljačić L, et al. Biological Evaluation and Conformational Preferences of Ferrocene Dipeptides with Hydrophobic Amino Acids. Inorganics. 2023; 11(1):29. https://doi.org/10.3390/inorganics11010029
Chicago/Turabian StyleKovačević, Monika, Mojca Čakić Semenčić, Ivan Kodrin, Sunčica Roca, Jana Perica, Jasna Mrvčić, Damir Stanzer, Krešimir Molčanov, Valentina Milašinović, Lidija Brkljačić, and et al. 2023. "Biological Evaluation and Conformational Preferences of Ferrocene Dipeptides with Hydrophobic Amino Acids" Inorganics 11, no. 1: 29. https://doi.org/10.3390/inorganics11010029
APA StyleKovačević, M., Čakić Semenčić, M., Kodrin, I., Roca, S., Perica, J., Mrvčić, J., Stanzer, D., Molčanov, K., Milašinović, V., Brkljačić, L., & Barišić, L. (2023). Biological Evaluation and Conformational Preferences of Ferrocene Dipeptides with Hydrophobic Amino Acids. Inorganics, 11(1), 29. https://doi.org/10.3390/inorganics11010029

